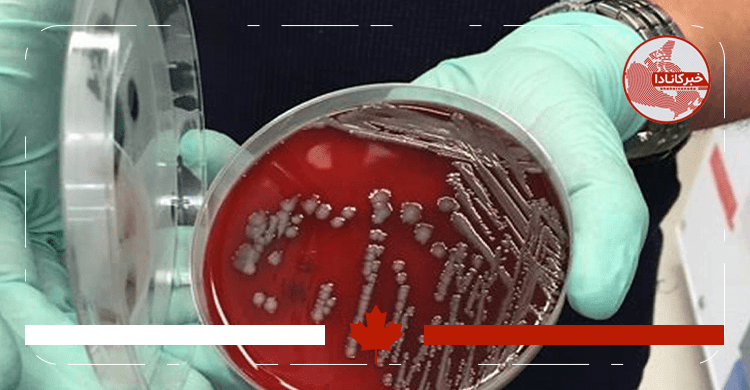

به همت محققان کانادایی: ابداع روشی جدید و ساده برای تشخیص باکتری سالمونلا
باکتری سالمونلا در برخی موادغذایی مانند مرغ، تخممرغ، محصولات پروتئینی، لبنیات و حتی برخی شکلاتها وجود داشته و میتواند باعث بروز مسمومیتهای غذایی و مشکلات جدی گوارشی در افراد شود. این باکتری حتی میتواند تخمدانهای پرندگان را آلوده کرده و پیش از تخم گذاشتن پرنده، وارد تخممرغهای آن شود یا اینکه در هنگام تخم گذاشتن پرنده، به پوسته تخممرغ نفوذ کرده و آن را آلوده کند.
پژوهشگران دانشگاه مکمستر کانادا به تازگی موفق به ابداع روشی شدهاند که به سرعت و به سادگی این باکتری را تشخیص میدهد. آزمایش سریع و ارزانقیمت این محققان میتواند آلودگی سالمونلا را در غذاها و موادغذایی تشخیص دهد. قابل توجه است استفاده از این آزمایش حتی از تست خانگی کووید۱۹ نیز راحتتر است.
محققان دانشگاه مک مستر کانادا راهحلی برای شناسایی باکتری سالمونلا ابداع کردهاند. آنها تست سریع و ارزان قیمت جدیدی ایجاد کردهاند که میتواند آلودگی سالمونلا را در انواع موادغذایی تشخیص دهد.
کارلوس فیلیپه (Carlos Filipe)، رئیس بخش مهندسی شیمی دانشگاه مکمستر، در توضیح به کارگیری چنین روش آزمایشی گفت: «استفاده از این کیت آزمایشی از آزمایش های خانگی کووید۱۹ آسانتر است. این آزمایش میتواند در عرض یک ساعت یا کمتر، بدون هیچ گونه لوازم جانبی یا منبع تغذیه، نتیجه را ارائه دهد. با توجه به اینکه در حال حاضر روش های آزمایشگاهی تشخیص باکتری فوق حداقل یک روز کامل زمان میبرد، ابداع این روش جدید اهمیت بسیار زیادی برخوردار است.»
سالمونلا یکی از شایعترین عفونتهای منتقله از طریق موادغذایی است که هر ساله باعث مرگ ۱۵۵ هزار نفر در سراسر جهان میشود. تولیدکنندگان طیور با کمک این کیت آزمایشی میتوانند محصولات طیور را که منبع اصلی عفونت هستند را کنترل کنند. در واقع کنترل این باکتری در مبدا دارای اهمیت زیادی است. این آزمایش همچنین میتواند به اطمینان از پردازش ایمن تخممرغ، گوشت چرخکرده و محصولات لبنی نیز کمک کند.
یینگفو لی (Yingfu Li)، استاد بیوشیمی و زیستشناسی شیمیایی که سرپرستی گروه تحقیقاتی اسیدهای نوکلئیک عملکردی دانشگاه مکمستر را بر عهده دارد در رابطه با موضوع فوق میگوید: «هر کسی میتواند دقیقا در محیطی که غذا آماده، پردازش یا فروخته میشود، از این تست ارزان، قابل اعتماد و آسان استفاده کند.»
در ضمن، دکتر توحید دیدار، دانشیار ایرانی-کانادایی در مهندسی مکانیک علوم نانو موادزیستی نیز در این رابطه گفت: «وجود چنین روش آسان و ارزانی جهت تشخیص باکتری سالمونلا در توسعه برنامه آزمایش موادغذایی بسیار مهم است. اینکه بتوان در عرض یک ساعت این باکتری را تشخیص داد از اهمیت بالایی برخوردار است.»
شرح کامل این تحقیقات و نتایج به دست آمده از آن به تازگی در مجله تخصصی Angewandte Chemie منتشر شده است.
سیستم جدید آزمایش سالمونلا چگونه کار میکند؟
محققان دانشگاه مکمستر یک مولکول مصنوعی ساختند که بین ذرات میکروسکوپی مانند طلا قرار گرفته است. هنگامی که یک نمونه مایع از غذا را روی پیپت آزمایشگاه قرار میدهیم، در صورت آلوده بودن، ذرات از هم جداشده و مولکول مصنوعی میتواند فرار کند.
هنگامی که محلول روی نوار تست کاغذی ریخته شود، نمونه آلوده به لطف حسگر زیستی ایجادشده روی نوار تست، به رنگ قرمز درآمده و هر چه میزان باکتری سالمونلا بیشتر باشد، لکه قرمز واضحتر میشود.